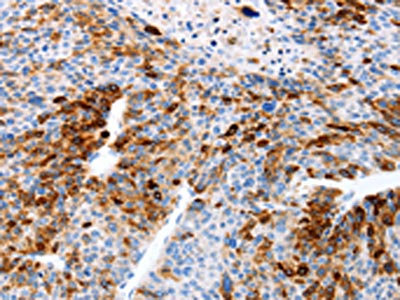

TFF1 Antibody
-
中文名稱:TFF1兔多克隆抗體
-
貨號:CSB-PA160693
-
規(guī)格:¥1100
-
圖片:
-
The image on the left is immunohistochemistry of paraffin-embedded Human cervical cancer tissue using CSB-PA160693(TFF1 Antibody) at dilution 1/20, on the right is treated with fusion protein. (Original magnification: ×200)
-
The image on the left is immunohistochemistry of paraffin-embedded Human liver cancer tissue using CSB-PA160693(TFF1 Antibody) at dilution 1/20, on the right is treated with fusion protein. (Original magnification: ×200)
-
Gel: 10+12%SDS-PAGE, Lysate: 40 μg, Lane: Mouse intestinum tenue tissue, Primary antibody: CSB-PA160693(TFF1 Antibody) at dilution 1/350, Secondary antibody: Goat anti rabbit IgG at 1/8000 dilution, Exposure time: 2 minutes
-
-
其他:
產品詳情
-
Uniprot No.:
-
基因名:
-
別名:BCEI antibody; Breast cancer estrogen inducible protein antibody; Breast cancer estrogen inducible sequence antibody; Breast cancer estrogen-inducible protein antibody; D21S21 antibody; Gastrointestinal trefoil protein antibody; Gastrointestinal trefoil protein pS2 antibody; hP1.A antibody; HP1A antibody; HPS 2 antibody; HPS2 antibody; pNR 2 antibody; PNR-2 antibody; pNR2 antibody; Polypeptide P1.A antibody; Protein pS2 antibody; PS 2 antibody; pS2 antibody; pS2 protein antibody; TFF 1 antibody; TFF1 antibody; TFF1_HUMAN antibody; Trefoil factor 1 antibody
-
宿主:Rabbit
-
反應種屬:Human,Mouse
-
免疫原:Fusion protein of Human TFF1
-
免疫原種屬:Homo sapiens (Human)
-
標記方式:Non-conjugated
-
抗體亞型:IgG
-
純化方式:Antigen affinity purification
-
濃度:It differs from different batches. Please contact us to confirm it.
-
保存緩沖液:-20°C, pH7.4 PBS, 0.05% NaN3, 40% Glycerol
-
產品提供形式:Liquid
-
應用范圍:ELISA,WB,IHC
-
推薦稀釋比:
Application Recommended Dilution ELISA 1:2000-1:5000 WB 1:500-1:2000 IHC 1:25-1:100 -
Protocols:
-
儲存條件:Upon receipt, store at -20°C or -80°C. Avoid repeated freeze.
-
貨期:Basically, we can dispatch the products out in 1-3 working days after receiving your orders. Delivery time maybe differs from different purchasing way or location, please kindly consult your local distributors for specific delivery time.
-
用途:For Research Use Only. Not for use in diagnostic or therapeutic procedures.
相關產品
靶點詳情
-
功能:Stabilizer of the mucous gel overlying the gastrointestinal mucosa that provides a physical barrier against various noxious agents. May inhibit the growth of calcium oxalate crystals in urine.
-
基因功能參考文獻:
- Findings suggest that the hypoxic conditions, which can be induced by gastric injury, promote TFF1 up-regulation, strengthened by an auto-induction mechanism, and that the trefoil peptide takes part in the epithelial-mesenchymal transition events eventually triggered to repair the damage. PMID: 29997345
- The urine TFF1 and TFF3 levels significantly increased with the progression of chronic kidney disease stages, but not the urine TFF2 levels. PMID: 29850501
- Study shows that TFF1 expression is silenced in early phases of esophageal squamous cell carcinoma (ESCC) development, which seems to be mediated at least in part by promoter hypermethylation, and provides the basis for the use of TFF1 expression as a potential biomarker for early ESCC detection. PMID: 29296124
- these data suggest that TFF1 might help cells to counteract Helicobacter colonization and the development of a chronic inflammation. PMID: 29085807
- Co-expression of GKN2 and TFF1 massively suppressed the expression of positive cell cycle regulators and induced G1/S arrest, synergistically enhancing the inhibition of cell viability and proliferation of gastric cancer cells PMID: 28150071
- The data suggest that the tumor suppressor activity of both RUNX1t1 and TFF1 are mechanistically connected to CEBPB and that cross-regulation between CEBPB-RUNX1t1-TFF1 plays an important role in gastric carcinogenesis. PMID: 27522676
- Low TFF1 expression is associated with retinoblastoma. PMID: 28481041
- The results suggest that the analysis of expression of MUC5AC and TFF1 may be useful for differentiating sessile serrated adenomas/polyps (SSA/Ps) from hyperplastic polyps (HPs). PMID: 28430953
- TFF1 displays a distinct protein expression pattern in the developing of airway remodeling due to Sulfur mustard inhalation and plays an important role in maintaining the airway epithelium function PMID: 27921407
- we found TFF1 plays an oncogenic role in mucinous ovarian cancer PMID: 26617749
- These results show increased levels of TFF1 and TFF3 in Chronic Kidney Disease patients with a pronounced elevation of urinary TFF1 in lower Chronic Kidney Disease stages. PMID: 26390128
- Loss of TFF1 could be a critical step in promoting the H. pylori-mediated oncogenic activation of beta-catenin and gastric tumorigenesis. PMID: 25980439
- We have established a novel, three-protein biomarker panel that is able to detect patients with early-stage pancreatic cancer in urine specimens:LYVE-1, REG1A, and TFF1 were selected as candidate biomarkers PMID: 26240291
- These findings suggest that the rs184432 and rs225359 polymorphisms in TFF1 have protective effects for GC and contribute to the development of GC in Korean individuals. PMID: 26240479
- Findings underscore an important protective role of TFF1 in abrogating H. pylori-mediated inflammation, a crucial hallmark of gastric tumorigenesis. Loss of TFF1 expression could be an important step in H. pylori-mediated gastric carcinogenesis. PMID: 26372254
- This study provides a potent tool of rTFF1 production to be applied in gastric damage protection and wound healing. The protein sources from B. choshinensis were more efficient than rTFF1 produced by E. coli PMID: 25990322
- trefoil factor 1 demonstrated breast specificity but was inferior to mammaglobin and GATA protein binding 3 PMID: 26276775
- Data indicate that microRNA miR218-5p negatively regulates trefoil factor 1 (TFF1) in an extracellular signal-regulated kinases Erk1/2-dependent manner. PMID: 25652124
- Trefoil Factor 1 levels can influence copper excretion and copper related toxicity. PMID: 25486181
- data clearly show that the expression of TFF3 in retinoblastoma cell lines is epigenetically regulated, whereas the level of TFF1 and TFF2 seems to be regulated by other or additional mechanisms PMID: 25199519
- Western blot analysis data demonstrated that miR-504 abrogates TFF1-induced p53 protein expression and activity. PMID: 25015107
- overexpressed in chronic rhinosinusitis without nasal polyps PMID: 24733740
- Immunohistochemical expression of ERalpha, ERbeta, and TFF1 in type I and II ovarian tumors. PMID: 24162262
- Determination of TFF1 status might identify patients at different risk for relapse and help in making decision on administering adjuvant therapy for early breast cancer patients during the first 3 years of follow-up. PMID: 24843314
- Retinoblastoma cell lines with high TFF1 expression levels exhibited a selective down-regulation of cyclin-dependent kinase (CDK) 6, whereas CDK4 and CDK2 seem to be unaffected by TFF1 expression. PMID: 22983508
- Piezo1 is a novel TFF1 binding protein that is important for TFF1-mediated cell migration in gastric cancer cells. PMID: 24798994
- the C-terminus of TFF1, involved in the binding of copper, is also able to selectively bind H. pylori RF-LPS. PMID: 24236136
- High TFF1 expression is associated with doxorubicininduced apoptosis resistance. PMID: 23836323
- miRNA-423-5p negatively regulated the expression of TFF1 by binding to its 3'UTR and participated in proliferation/invasion-related processes via a TFF1-dependent manner in gastric cancer cells PMID: 24486742
- TFF1 missense mutations seem to be a rare event in colorectal carcinogenesis. However, serum TFF1 levels were significantly elevated in patients with colorectal carcinoma. Serum TFF1 may be a potential useful marker for patients with colorectal carcinoma. PMID: 24503794
- Analysis of TFF1 levels dynamics revealed that TFF1 levels kept steady state during the 5-day period. TFF1 levels were similar in patients with SIRS, sepsis and severe sepsis PMID: 23627615
- MSK1 and MSK2 are required for maximal TFF 1 induction. PMID: 23675462
- downregulation of TFF1 expression during gastric neoplastic transformation is associated with activation of the NF-kappaB pathway PMID: 23942618
- TFF1 expression is silenced by DNA methylation and is associated with tumor invasion and a poor survival in gastric cancer patients. PMID: 23291975
- Reduced expression of TFF1 and increased expression of TFF3 may play a role in the carcinogenesis of gastric cancer. PMID: 23329884
- There is no direct molecular interaction between GKN1 and TFF1 in protein level in gastric cancer. PMID: 22842654
- The capacity of TFF1 to enhance prostate cancer cell migration/invasion is mediated by transcriptional repression of E-CADHERIN. PMID: 23266572
- The expression of TFF1 protein increases in gastric ulcer but decreases in gastric ulcerocancer. PMID: 22944057
- Report TFF1 expression in normal/diseased pancreas. PMID: 22286382
- Over-expression of TFF1 could promote apoptosis of three cell lines and inhibit proliferation but had no pronounced effect on cell cycle PMID: 22642590
- gastrointestinal tract specific gene GDDR might inhibit gastric cancer growth in a TFF1 dependent manner. PMID: 21870107
- PIMT may act as a co-activator in ERalpha-mediated transcription of TFF1 through its recruitment to the promoter via interacting with ERalpha. PMID: 22382029
- TFF1 promoter methylation is identified as a potential early marker of esophageal squamous cell carcinoma (ESCC). PMID: 21946330
- We found a statistically significant increased risk of gastric cancer associated with -394 TT genotypes PMID: 22093877
- documented the extent and timing of TFF1 expression in pancreatic ductal adenocarcinoma PMID: 21747314
- expression of TFF1 stimulated the migration and invasion in the four cell lines. Forced TFF1 expression in MCF10A, MDA-MB-231 and MCF7 cells did not modify anchorage-dependent or -independent cell proliferation PMID: 21358676
- The TFF1 promoter is activated by serum depletion according to promoter reporter assays in HEK 293 cells. PMID: 20494980
- TFF mRNA/protein expression is indicative of cholangiocarcinoma progression, but not predictive for histological sub-type or survival time. PMID: 21472131
- Data show that genes overexpressed in breast carcinoma including TFF1, TFF3, FOXA1 and CA12. PMID: 20132413
- loss of TFF1 leads to activation of IKK complex-regulated NF-kappaB transcription factors and is an important event in shaping the NF-kappaB-mediated inflammatory response during the progression to gastric tumorigenesis PMID: 21490402
顯示更多
收起更多
-
亞細胞定位:Secreted.
-
組織特異性:Found in stomach, with highest levels in the upper gastric mucosal cells (at protein level). Detected in goblet cells of the small and large intestine and rectum, small submucosal glands in the esophagus, mucous acini of the sublingual gland, submucosal g
-
數據庫鏈接:
Most popular with customers
-
-
Phospho-YAP1 (S127) Recombinant Monoclonal Antibody
Applications: ELISA, WB, IHC
Species Reactivity: Human
-
-
-
-
-
-